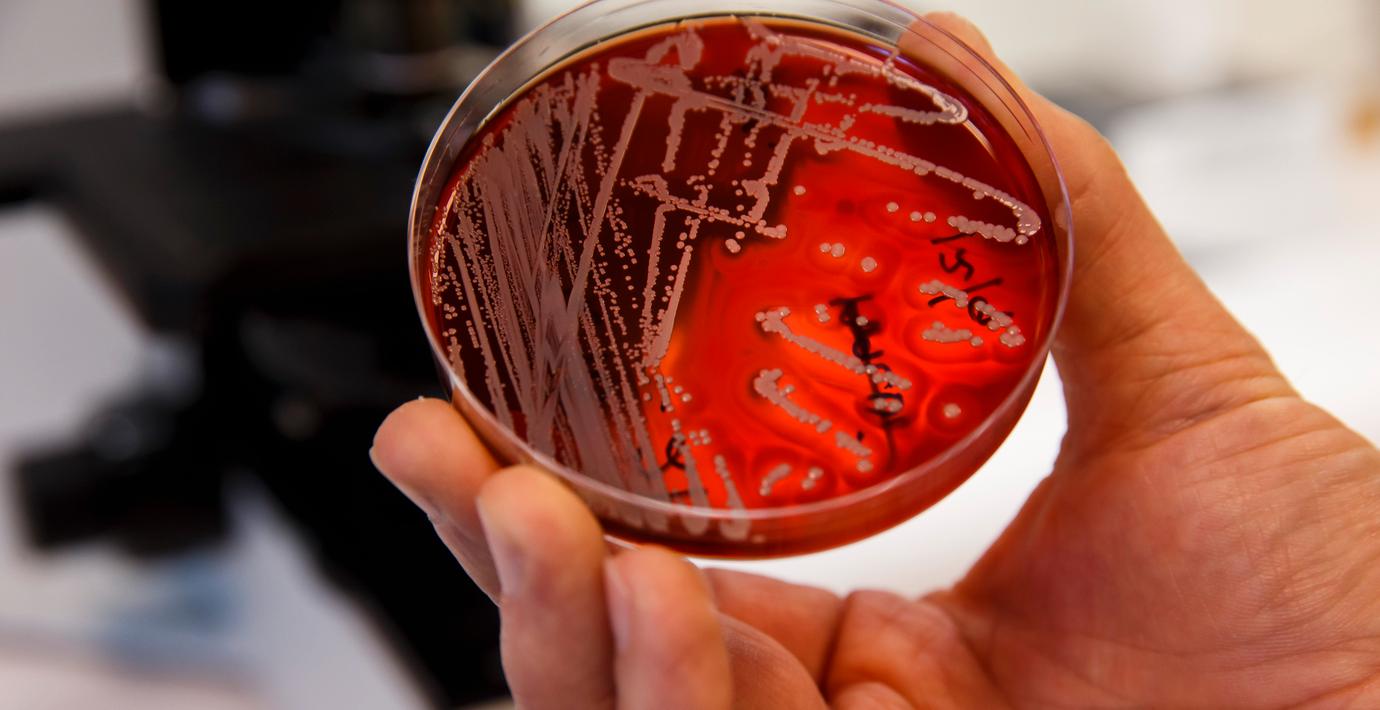

Nyupptäckt bakterie får sitt namn efter Göteborg
En nyligen upptäckt bakterie kommer att få namn efter Göteborg, skriver GP. Den antibiotikaresistenta bakterien, som ingår i samma familj som E.coli och Salmonella, ska heta Scandinavium goeteborgense.
Bakterien upptäcktes i ett infekterat sår hos en patient på Kungälvs sjukhus.
– Det var ett sätt att hedra Skandinavien och Göteborg, säger ansvarige forskaren Hedvig Engström Jakobsson till tidningen.
Omni är politiskt obundna och oberoende. Vi strävar efter att ge fler perspektiv på nyheterna. Har du frågor eller synpunkter kring vår rapportering? Kontakta redaktionen